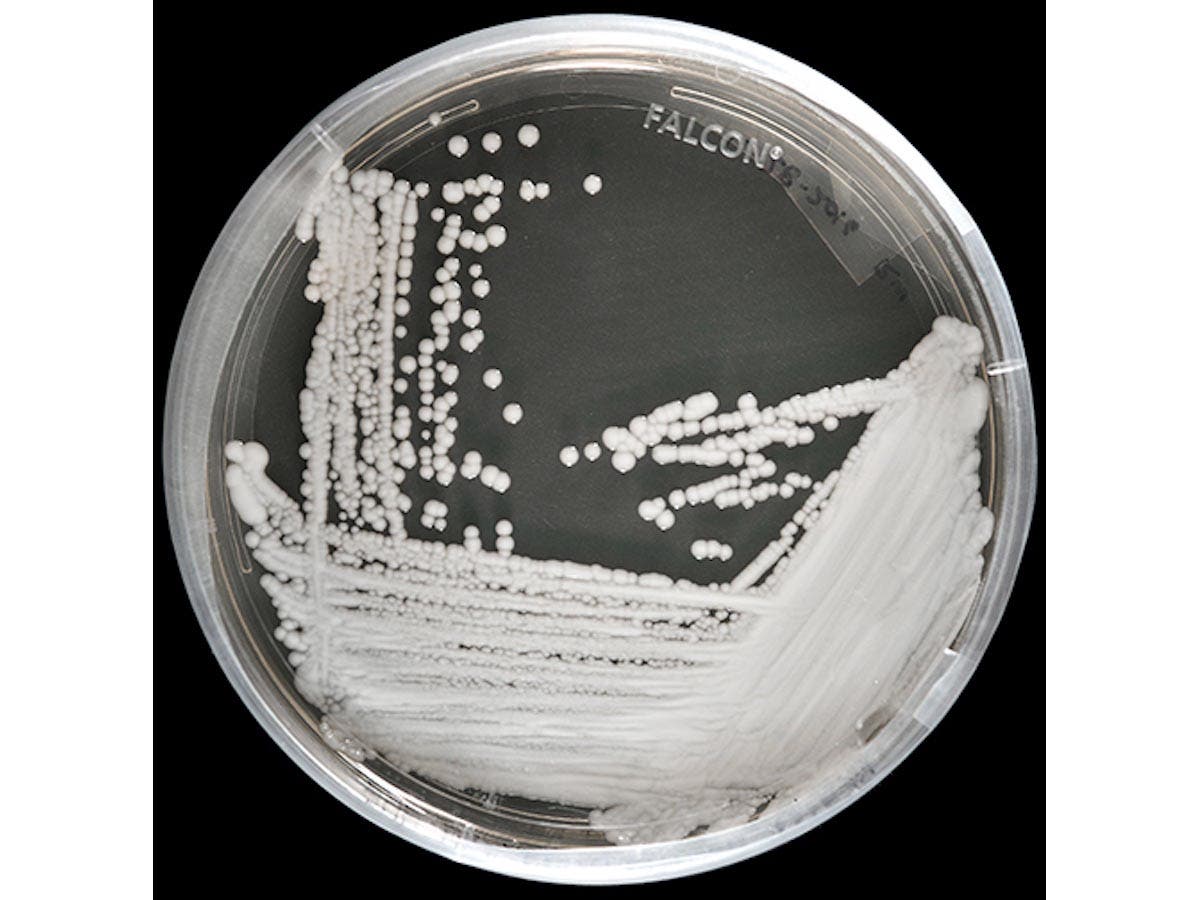

Community Corner
'Superbug' Strikes New York Hospitals; 44 Infected And Growing
N.Y. has the highest infection rate from a "superbug," a potentially deadly fungus that has increased 800 percent since the fall.
A potentially deadly "superbug" has struck New York, where hospitals are dealing with the highest rate of infection in the country, according to the Centers for Disease Control and Prevention. Sixty-six cases of "Candida auris," a multi-drug-resistant fungus that is emerging globally, have been identified in New York and elsewhere in the United States, according to the CDC.
New York has had 44 cases, followed by New Jersey with 15 cases. The remaining states with reported cases are Illinois, with 4; and Indiana, Maryland and Massachusetts, each with one.
“It’s acting like a superbug," said Paige Armstrong, CDC Epidemic Intelligence Service officer. "Without appropriate infection control and really a rigorous response, [it] could lead to even more cases in the United States.”
Find out what's happening in Miller Place-Rocky Pointfor free with the latest updates from Patch.
Armstrong said the increase in global cases and travel have likely had an impact on the United States, where cases have increased by more than 800 percent since the fall. But the CDC said it couldn't explain why New Jersey and New York have had the biggest impact.
"It's a great question," said Sharon Tsay, also a CDC EIS officer, noting that the area is a major population center, which would increase the likelihood of being infected with the fungus.
Find out what's happening in Miller Place-Rocky Pointfor free with the latest updates from Patch.
All of the New York cases, besides one in Rochester, have been reported in New York City– at 15 hospitals and one doctor's office, CBS 2 reported.
Those who have been in the intensive care unit for a long time or have a central venous catheter placed in a large vein, and have previously received antibiotics or antifungal medications, appear to be at highest risk of infection with this yeast, the CDC said.
The fungus was first found in a man’s ear in Japan in 2009, according to the CDC. The first case in New York was reported in May 2013.
Seventeen people who have been infected with the fungus in New York have died, but they all had other illnesses and "the fungus was not necessarily the cause of death," state officials told the Associated Press.
Candida auris grows as yeast, and symptoms include difficulty swallowing, burning, genital itching and sometimes a cheese-like discharge that looks white, according to the CDC.
Neil Gaffin, an infectious disease specialist at the Valley Hospital in Ridgewood, N.J., told CBS 2 that the organism can be spread patient to patient, as well as via "environmental surfaces."
“What’s also unique about this organism is that it can actually stay on skin surfaces for prolonged periods of time, even months after the initial infection is cured,” Gaffin told CBS.
Most of the Candida auris strains from U.S. patients showed some drug resistance, making treatment more difficult. Samples of Candida auris strains from other countries have been found to be resistant to all three major classes of antifungal medications.
Armstrong spoke publicly at a conference in Atlanta last week about the Candida auris, saying emerging multidrug-resistant fungus is "acting like a bacteria."
Armstrong said the impact on medical practitioners is apparent, noting that Colombia's neonatal intensive care units have been suffering through enduring outbreaks of Candida auris.
“What we were able to find out is that, in fact, it is colonized in people even after you get treated with antifungal medications, people still have it on their skin," Armstrong said at the conference. "And so this is something that we’ve never seen before with a fungus, or I should say we don’t usually see with a fungus."
Written by Tom Davis
CDC Photo
Get more local news delivered straight to your inbox. Sign up for free Patch newsletters and alerts.